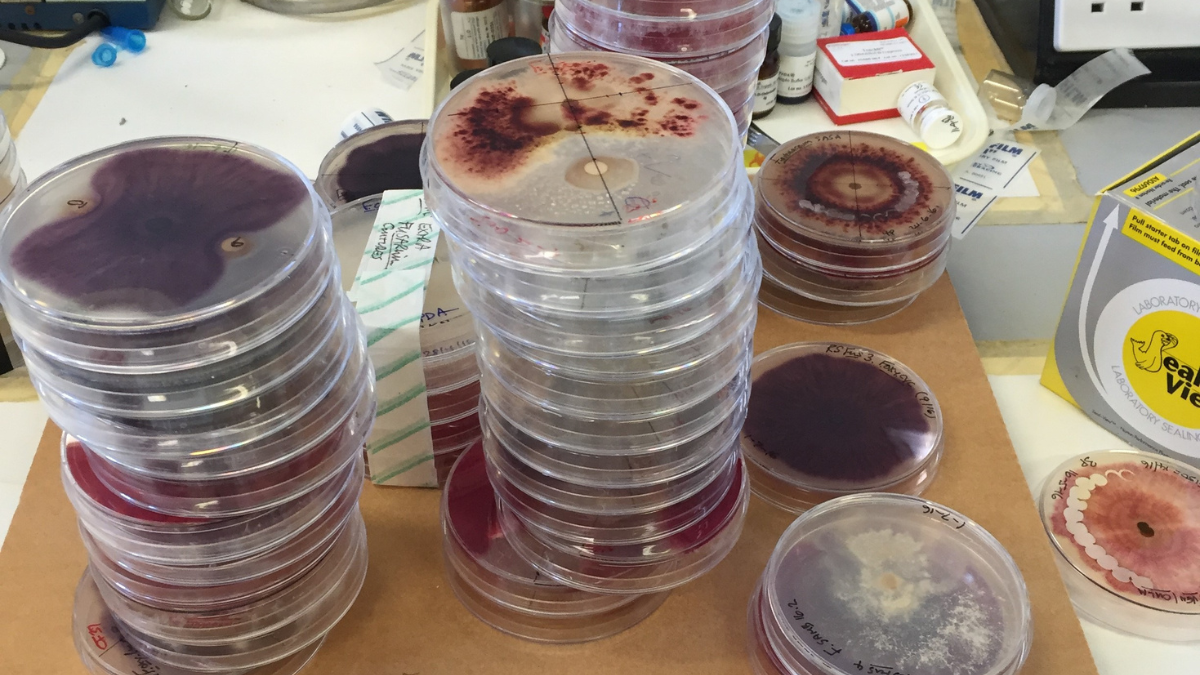
FDCHistory_Petri dishes Queens_BlogPostArticleImage1200x675

Fusarium patch remains the most common and widespread fungal disease problem in cool season turfgrasses. The fungus Microdochium nivale causes Fusarium patch disease and penetrates the leaf through the stomata. Microdochium nivale is a cold-loving fungus. It is well adapted to causing damage in cold, wet conditions.
The work you put into producing a high-quality playing surface throughout the whole growing season can be damaged rather quickly. The resulting damage often takes a long time to recover, and you have to struggle to get the turf ready for the next season to start.
That was the starting point for the development of the FDC foliar defence system and is the same challenge today. Over the years, a lot of research has gone into developing the product and proofing its effectiveness by scientifically conducted In-vitro, glass house and field trials.
Microdochium nivale

Microdochium nivale mycelium
2006-2007-2008
Carsten Marker and Bjarne Palsov, responding to demands from customers, started to develop product ideas and realised them with Dr. Neil Baldwin, the very talented director at the time of a private label manufacturer in the UK. Following the development and formulation of FDC, a series of independent research disease control trials were commissioned.
The First of these took place at Woburn Golf Course, UK and was managed by Agrochemex, an independent research organisation.
Woburn Golf Course, UK
The Second trial took place at Skovlunde Golf Course, Denmark and was carried out by the University of Aarhus Faculty of Agricultural Sciences Department of Integrated Pest Management.
Those trials showed a dramatic increase in plant health. The product really worked.
Woburn Golf Course, UK
The product was marketed as a hardener for grass. Turf should be strengthened by natural means so that disease is discouraged. It did not have a direct effect on the disease-causing fungi, but instead targeted the grass plant, greatly improving the resistance to attack. The product was developed as part of Integrated Disease Management (IDM), namely to employ all mechanical, biological and chemical tools to make the plant as disease resistant as possible.
At this time, the product depended on a lot of iron in the formulation.
Untreated
Treated
2011
By now, company ownership of the supplier had changed, but the formulation of FDC is owned by E. Marker and is consistently marketed under the brand TourTurf®.
Tim Baldwin, Neil Baldwin's son, has now taken over the production and continuous adaptation and development of the product.
Tim Baldwin and Carsten Marker, Hittfeld 2013
EITS Trials, Hittfeld 2011
In Autumn 2011, the European Institute of Turfgrass Science (EITS) made trials of an advanced formulation of the product at Golf Club Hittfeld, Hamburg, Germany. Doug Karcher, PhD and John Sorochan, PhD evaluated turf coverage and green colour.
They concluded: “The TourTurf® FDC treatment provided darker green colour and greater turf cover than the Stratego and control plots. In addition, there were no occurrences of Fusarium on either the TourTurf® FDC plots or the control plots; however, two of the Stratego plots showed minor incidence of Fusarium.”
2012-2013
The Department of Plant Pathology at the University of Wisconsin annually conducts an extensive programme of snow mould control testing. These independent trials evaluate over 60 different fungicides and fungicide combinations for the control of Microdochium nivale.

Although TourTurf® FDC is an alternative to a fungicide, it was trialled to compare the effectiveness against market leading fungicides. This evaluation was conducted at Odana Hills Golf Course in Madison, WI on a creeping bentgrass (Agrostis stolonifera) and Poa annua green. Odana Hills GC was chosen as the site to conduct the trials as it has extensive snow mould activity. The winter weather conditions in Wisconsin are similar to the winter conditions in Scandinavia and Western Europe.
FDC was advertised as: "Tested in the US"
The study found that TourTurf® FDC gave a significant improvement in both turf quality and turf colour.
2018
Dr. Colin Fleming, Marion Hodel and colleagues conducted trials with an ever-evolving formulation of FDC at Agri-Food and Biosciences Institute and Queens University, Belfast.
Agri-Food and Biosciences Institute and Queens University, Belfast
They could document a significant increase of 19.3% in shoot weight:
Average Agrostis Shoot Weight (g) - Microdochium inoculated
There was also a significant increase in root weight, compared to the untreated control:
Average Agrostis Root length (cm) - Microdochium inoculated
2021-2022
Trials by Alec Kowalewski, PhD at Oregon State University confirmed the performance of FDC.
Oregon Trial-Area, March 18, 2022
FDC was applied every 4 weeks with an application rate of 40 L/ha with a CO2-pressurized backpack sprayer with a 4-nozzle boom outfitted with TeeJet 80015 flat fan nozzles, applying 815 L/ha total spray volume at 2.1 Bars. Walking speed was calibrated with a metronome.
Visual plot quality, turf colour without regard for disease, and percent disease ratings, were taken every 2 weeks during the trial, Additionally, average NDVI (Normalized Difference Vegetative Index) readings (9 per plot) were taken every 2 weeks using a FieldScout CM 1000 NDVI meter.
NDVI readings are thought to correlate with turf health and quality. Healthy turf produces an NDVI value between 0.70 and 0.92, depending on height of cut and fertility status.
The plots treated with the fungicide rotation had the highest plot quality throughout the trial because this is the only treatment that provided 100 percent disease control.
Plots treated with the two TourTurf® products applied together had nearly 2 percent disease on March 18. This level of disease produced unacceptable turf quality. These plots also had unacceptable turf quality on March 3. On all other dates, these plots were acceptable.
Looking at the colour and quality ratings for treatment 3 (TourTurf® FDC) on January 6, we can see that colour rated 8, but quality rated as 6.6 and 6.5, respectively
Uninfected Turf Colour
Oregon Trial-Area, March 18, 2022
2022-2023
The trials continued at Oregon State University to evaluate the combination of applications of TourTurf® FDC and TourTurf® High PK (High PK is sold only outside the EU presently) applied alone and together, and TourTurf® High PK + TourTurf® STA. They have been applied every 28 days for their effects on the turfgrass quality of a Poa annua putting green. A standard fungicide rotation was included in the trial as a comparison.
The final trial report from July 14, 2023, finds:
The effects of product and product over time on percent disease cover, turf quality, and turf colour were significant (Table 1). Regarding percent disease cover over time, TourTurf® High PK + TourTurf® STA, TourTurf® FDC + TourTurf® High PK, and the traditional fungicide rotation produced the lowest percent disease (Figure 1).
Figure 1: Effects of the product on percent disease over time (Nov 3, 2022 to March 23, 2023) in Corvallis, OR. Overlapping error bars represent a significant difference at a 0.05 level of probability. The fungicide rotation consisted of the following products, rates and dates: Banner Maxx (2.0 fl. oz./ 1,000ft2 or 6.36 L/ha on Oct 7th, Nov 3rd, and Dec 1st. Contend A (1.0 fl. oz./1,000ft2 or 3.18 L/ha) + Daconil WeatherStik (3.6 fl. oz./1,000ft2 or 11.5 L/ha) on Dec 28th, Affirm (0.88 wt. oz./1,000ft2 or 2.69 kg/ha) + Secure Action (0.50 fl. oz./1,000ft2 or 1.59 L/ha) on Jan 27th, and Turfcide 400 (8.0 fl. oz./1,000ft2 or 25.44 L/ha) on Feb 24th.
Control
FDC + High PK
High PK + STA
Regarding turf quality over time, TourTurf® High PK + TourTurf® STA, and TourTurf® FDC + TourTurf® High PK produced the most consistent high-quality turf overtime (Figure 2).
Figure 2: Effects of product on turf quality over time (Nov 3, 2022 to March 23, 2023) in Corvallis, OR. Overlapping error bars represent a significant difference at a 0.05 level of probability. The fungicide rotation consisted of the following products, rates, and dates: Banner Maxx (2.0 fl. oz./ 1,000ft2 or 6.36 L/ha on Oct 7th, Nov 3rd, and Dec 1st. Contend A (1.0 fl. oz./1,000ft2 or 3.18 L/ha) + Daconil WeatherStik (3.6 fl. oz./1,000ft2 or 11.5 L/ha) on Dec 28th, Affirm (0.88 wt. oz./1,000ft2 or 2.69 kg/ha) + Secure Action (0.50 fl. oz./1,000ft2 or 1.59 L/ha) on Jan 27th, and Turfcide 400 (8.0 fl. oz./1,000ft2 or 25.44 L/ha) on Feb 24th.
Regarding turf colour, TourTurf® FDC + TourTurf® High PK, TourTurf® FDC, and TourTurf® High PK + STA resulted in the greatest turf colour (Figure 3). The untreated control, standard fungicide rotation, and TourTurf® High PK applied alone resulted in the lowest turf colour.
Figure 3: Effects of product on turf colour over time (Nov 3, 2022 to March 23, 2023) in Corvallis, OR. Overlapping error bars represent a significant difference at a 0.05 level of probability. The fungicide rotation consisted of the following products, rates and dates: Banner Maxx (2.0 fl. oz./ 1,000ft2 or 6.36 L/ha on Oct 7th, Nov 3rd, and Dec 1st. Contend A (1.0 fl. oz./1,000ft2 or 3.18 L/ha) + Daconil WeatherStik (3.6 fl. oz./1,000ft2 or 11.5 L/ha) on Dec 28th, Affirm (0.88 wt. oz./1,000ft2 or 2.69 kg/ha) + Secure Action (0.50 fl. oz./1,000ft2 or 1.59 L/ha) on Jan 27th, and Turfcide 400 (8.0 fl. oz./1,000ft2 or 25.44 L/ha) on Feb 24th.
2023 Major product update
Since the initial formulation and development of FDC in 2006, the number of available fungicides to complement preventative nutritional measures has dropped.
The fertilizer laws in the EU have changed.
A high content of Iron like in the initial FDC product is not advisable on all golf courses using the product year after year.
That’s why the formulation has been adjusted once more. The product now contains less iron but additional Triacontanol.
Triacontanol is found naturally in the leaves of most plants and makes the plant feel less stressed and up-regulates photosynthesis, photorespiration and assimilation of CO2.
The focus is now once more on strengthening the plant and speeding up recovery and regrowing damaged turf after a disease attack in autumn.
What is FDC + Triacontanol?
TourTurf® FDC + Triacontanol has a designed foliar defence system and is a complete product for turf green-up and to prepare the turf for winter months. The combination of FDC and Triacontanol is a more sustainable option.
The addition of Triacontanol helps FDC perform better, justifying less iron in the product. This combination gives the turf the best conditions for optimal wintering and contributes to a faster recovery from the natural damage occurring during autumn and winter.
The Role of Triacontanol
Triaconatol structur
Triacontanol is an organic and naturally occurring fatty alcohol belonging to the class of compounds known as phytohormones. It is found naturally in various plant species.
Triacontanol is an endogenous plant growth regulator and facilitates numerous plant metabolic activities leading to better growth and development. Triacontanol increases the chlorophyll production, resulting in higher photosynthesis output and plant growth. It plays an essential role in alleviating plant stress from disease.
FDC + Triacontanol and Disease Prevention
The addition of 2% Triacontanol to FDC has been shown to improve disease preventative properties of the turf when studied under high intensity disease inoculation trials. FDC + Triacontanol performed better than a commercial fungicide up to 5 days post inoculation with Microdochium nivale and overall reduced disease spread compared to untreated (Fig. 1). Pots were treated 2 days before inoculation, and there was also some initial disease pressure in each treatment.
Fig. 1 Mycelium coverage measured twice a day from inoculation in FCD + Triacontanol, commercial fungicide and untreated pots. FDC + Triacontanol showed promising preventative properties compared to commercial fungicide and untreated before the intense disease pressure took hold. Error shows LSD5%.
Fig. 2 Photos taken of each treatment showing mycelium coverage and plant health.
FDC + Triacontanol Disease Recovery Potential
TourTurf® FDC + Triacontanol contains 5.5% Nitrogen and 3% Iron – this combination has a significant greening effect. Triacontanol improves nutrient uptake in the plant, making nitrogen and iron uptake in the plant more efficient. As a result, the addition of Triacontanol significantly improves plant disease recovery through increased chlorophyll production, resulting in higher photosynthesis output and plant growth.
Chlorophyll efficiency is calculated as a factor of sward density and colour.
Fig. 3 describes how the chlorophyll efficiency of the uninfected turf of FDC + Triacontanol is noticeably higher after inoculation compared to untreated and a commercial fungicide treatment.
Fig. 3 Chlorophyll efficiency calculated as a factor of sward density and colour of recovered or uninfected turf. The FDC + Triacontanol had a higher score compared to untreated pots and pots treated with a commercial fungicide.
TourTurf® FDC Autumn Foliar Defence Concept 6-0-0 + 3% Fe will not solve all your problems. It will not be possible to be 100% disease free during autumn. This can be clearly seen in a variety of studies.
But TourTurf® FDC Autumn Foliar Defence Concept 6-0-0 + 3% Fe can be an excellent tool in your toolbox to manage your challenges and get stunning results!